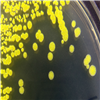

拉丁學名 Streptomyces violaceochromogenes
曾用名
中文譯名 紫產(chǎn)色鏈霉菌
原始編號 LMG 20271
菌株來源 ←中國科學院微生物研究所←LMG
保藏人 劉志恒
直接來源國家 比利時
保藏時間 5/1/2002
其他保藏編號 =ATCC 19932 =ATCC 25512 =CBS 654.69 =DSM 40181 =ISP 5181 =JCM 4530 =KCTC 19974 =NBRC 13100 =NRRL B-
生物危害 四類
模式菌株 模式菌株
菌株用途 模式菌株
培養(yǎng)溫度 28℃
培養(yǎng)基 0038
其他培養(yǎng)條件
分離源 土壤
采集地點
采集國家
Genbank(保藏人)
參考文獻
價格 B
提供形式 凍干物